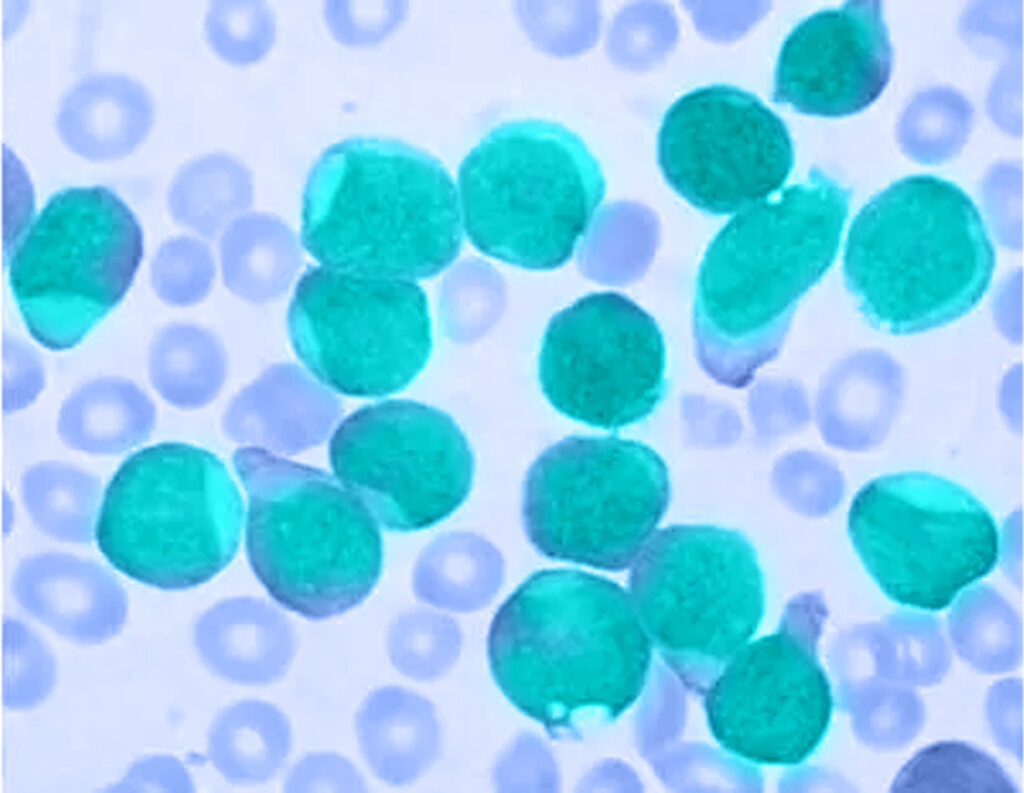

Pediatric rheumatic diseases are rare chronic inflammatory diseases that encompass a spectrum of imbalances that affect the musculoskeletal system and different organs, with Juvenile Idiopathic Arthritis being the most common chronic rheumatic disease. Young people who suffer from these diseases may experience pain, stiffness, fatigue, inflammation and other symptoms that can affect their ability to participate in daily activities and enjoy a full and healthy life.
World Day for Rheumatic Diseases in Youth (March 18) was promoted by the European Association of Pediatric Rheumatology (PReS) with the aim of raising awareness among the population that rheumatic diseases can also occur in childhood.
As a company dedicated to offering diagnostic solutions for more than 20 years, we want to make a statement about the ongoing challenges that arise in this area; “There are currently numerous highly effective treatments thanks to scientific progress and a greater understanding of diseases. However, delays in diagnosis and access to adequate care – with excellent and quality equipment – continue to be a focus for work in the health area,” says Carlos Jiménez, Co-Founder and General Manager of Microbac.
The World Day of Rheumatic Diseases of Youth (March 18) was promoted by the European Association of Pediatric Rheumatology (PReS) with the aim of raising awareness among the population that rheumatic diseases can also occur in childhood.

Microbac currently has the equipment Alegria®️ y Alegria2®️ within its product portfolio. Both devices are aimed at detecting antibodies associated with autoimmune diseases.
Today we want to reinforce the idea that rheumatic diseases are not exclusive to adults and that the best tool for their treatment is early detection and diagnosis.


